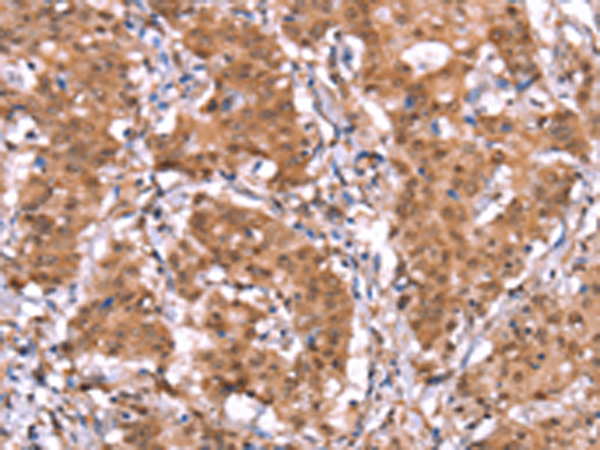
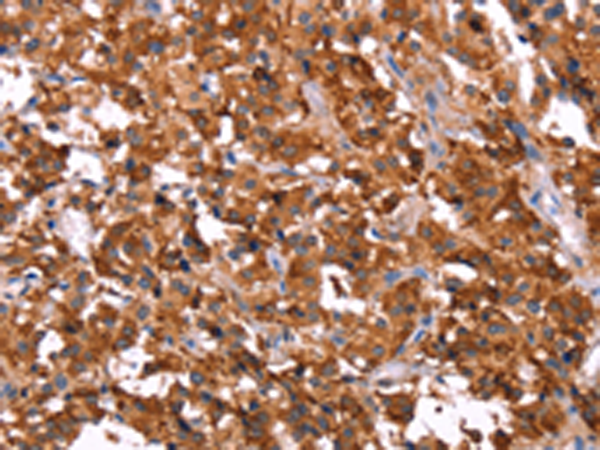

-
分类: 科研抗体货号: P11755别名: WTX; OSCS; FAM123B; RP11-403E24.2应用: IHC反应种属: Human, Mouse
-
分类: 科研抗体货号: P11734别名: p43; HLD3; EMAP2; SCYE1; EMAPII应用: WB,IHC反应种属: Human, Mouse
-
分类: 科研抗体货号: P11713别名: CDHF1; DG2/DG3应用: IHC反应种属: Human, Mouse
-
分类: 科研抗体货号: P11753别名: EXTL应用: IHC反应种属: Human, Mouse
-
分类: 科研抗体货号: P11733别名: FAE; LCE; FACE应用: IHC反应种属: Human
-
分类: 科研抗体货号: P11711别名: OPRD应用: IHC反应种属: Human, Mouse, Rat
-
分类: 科研抗体货号: P11752别名: GLP1; GLP2; GRPP应用: IHC反应种属: Human, Mouse, Rat
-
分类: 科研抗体货号: P11731别名: Q99; EIF2C; EIF2C1; GERP95应用: IHC反应种属: Human, Mouse
-
分类: 科研抗体货号: P11742别名: HRAS2; HRASP应用: WB,IHC反应种属: Human, Mouse
-
分类: 科研抗体货号: P11748别名: EAP2; AD022; EAPII; TTRAP; hTDP2; dJ30M3.3应用: WB,IHC反应种属: Human, Mouse

鄂公网安备42018502007531号
鄂公网安备42018502007531号

